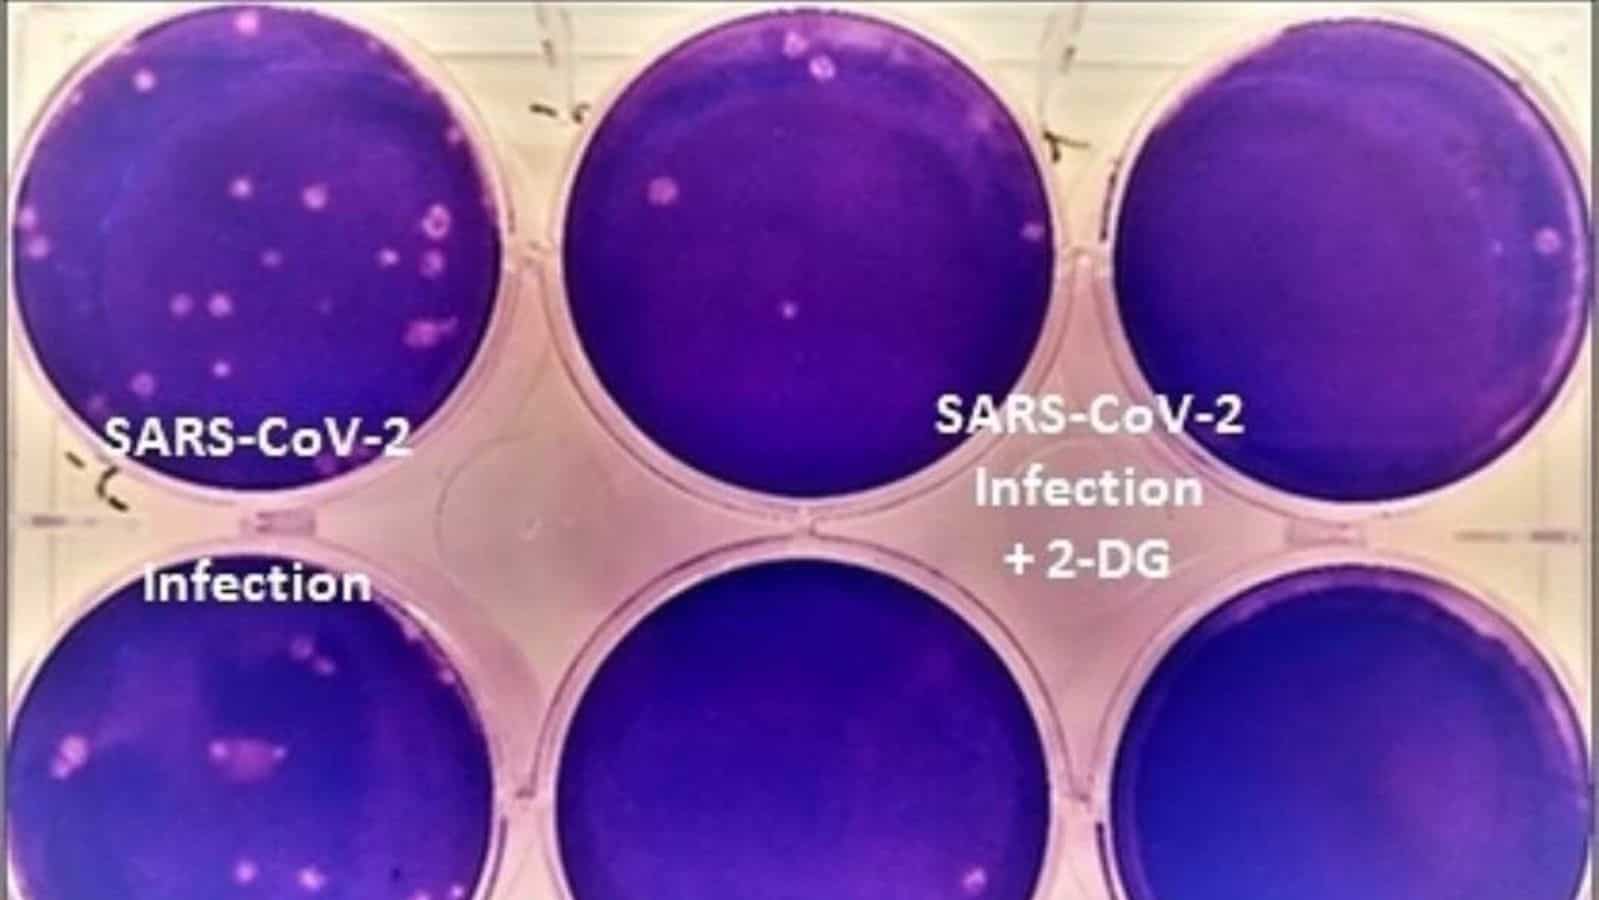
You are currently viewing The second batch of DRDO’s 2DG anti-covid drug in the market, the price was fixed by the center

On May 26, DRDO officials said that the second batch of 10,000 sachet will be delivered to Dr. Reddy’s lab tomorrow (today).
Zee24GhantaHealth News
2021-05-28 14:20:47
Source link
Zee24GhantaHealth News
2021-05-28 14:20:47
Source link